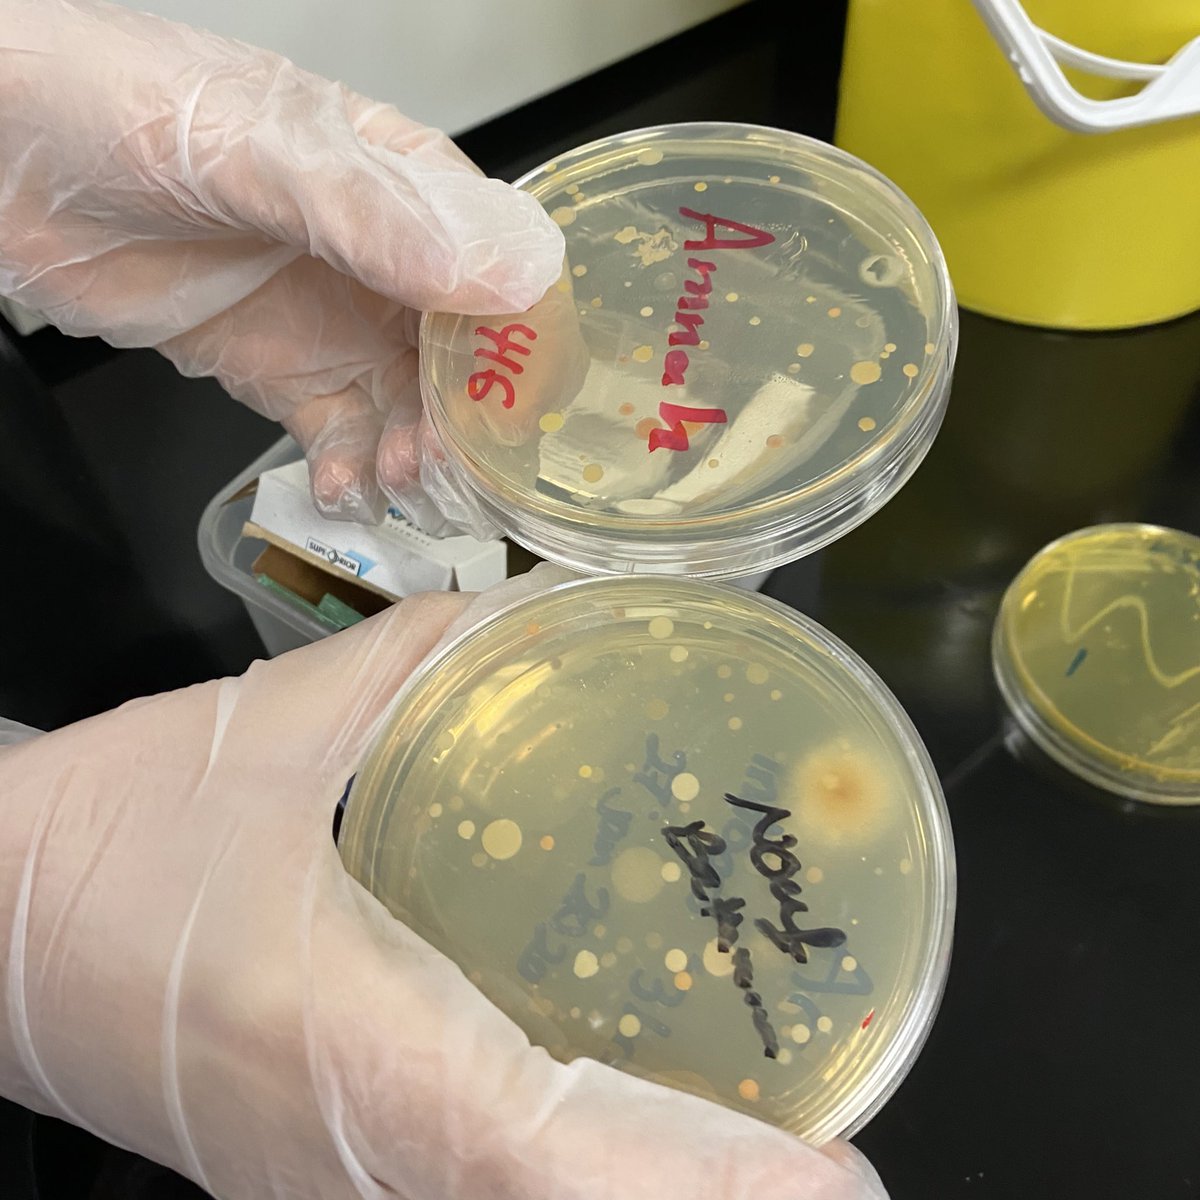
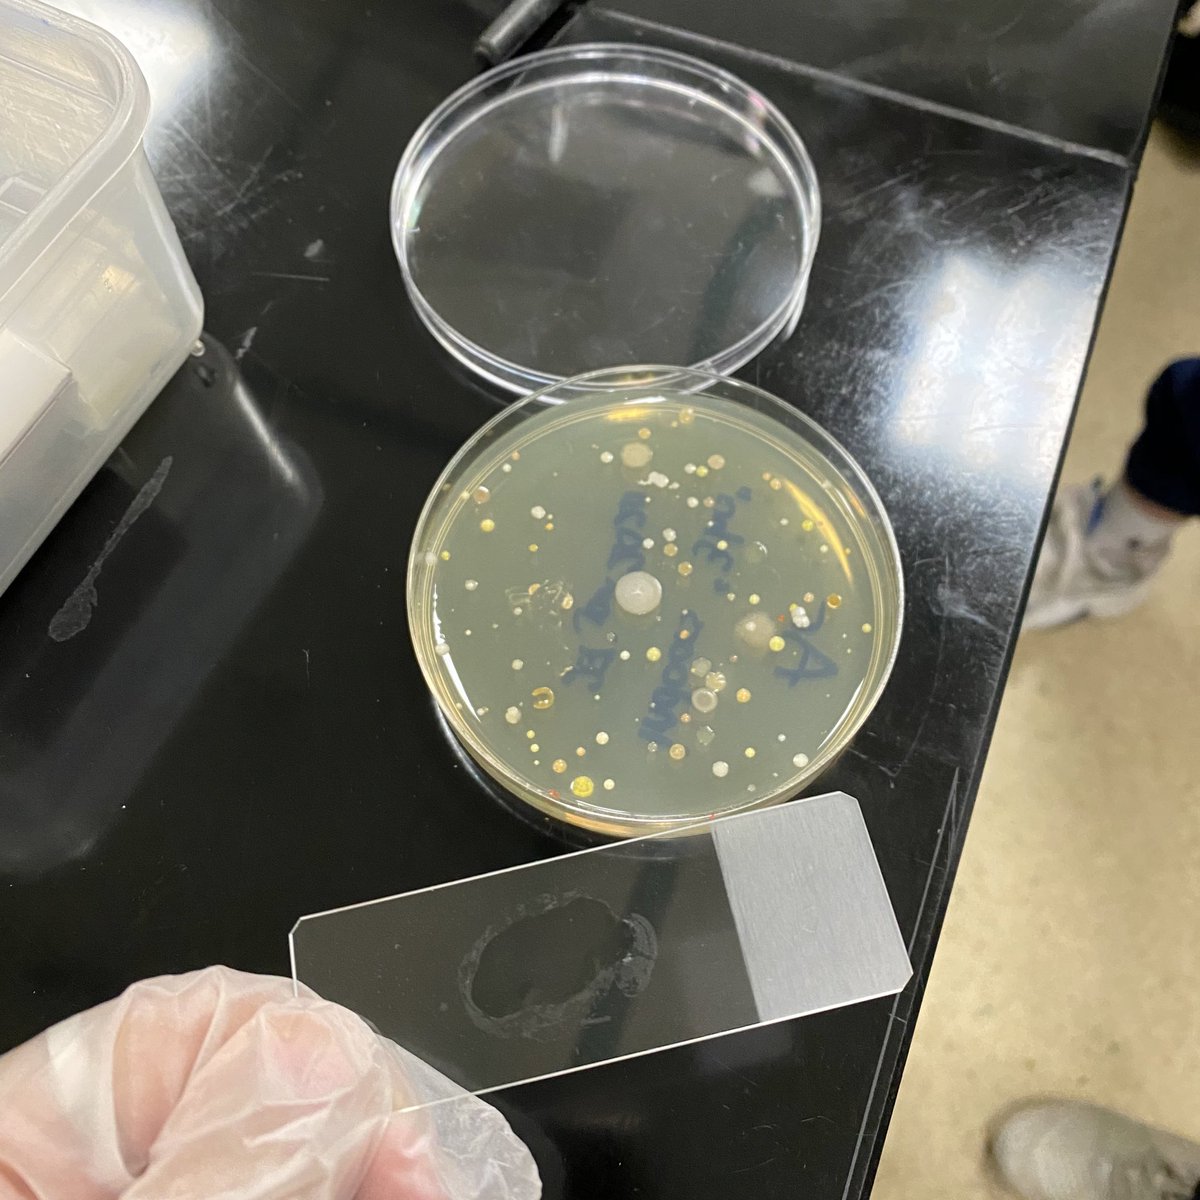
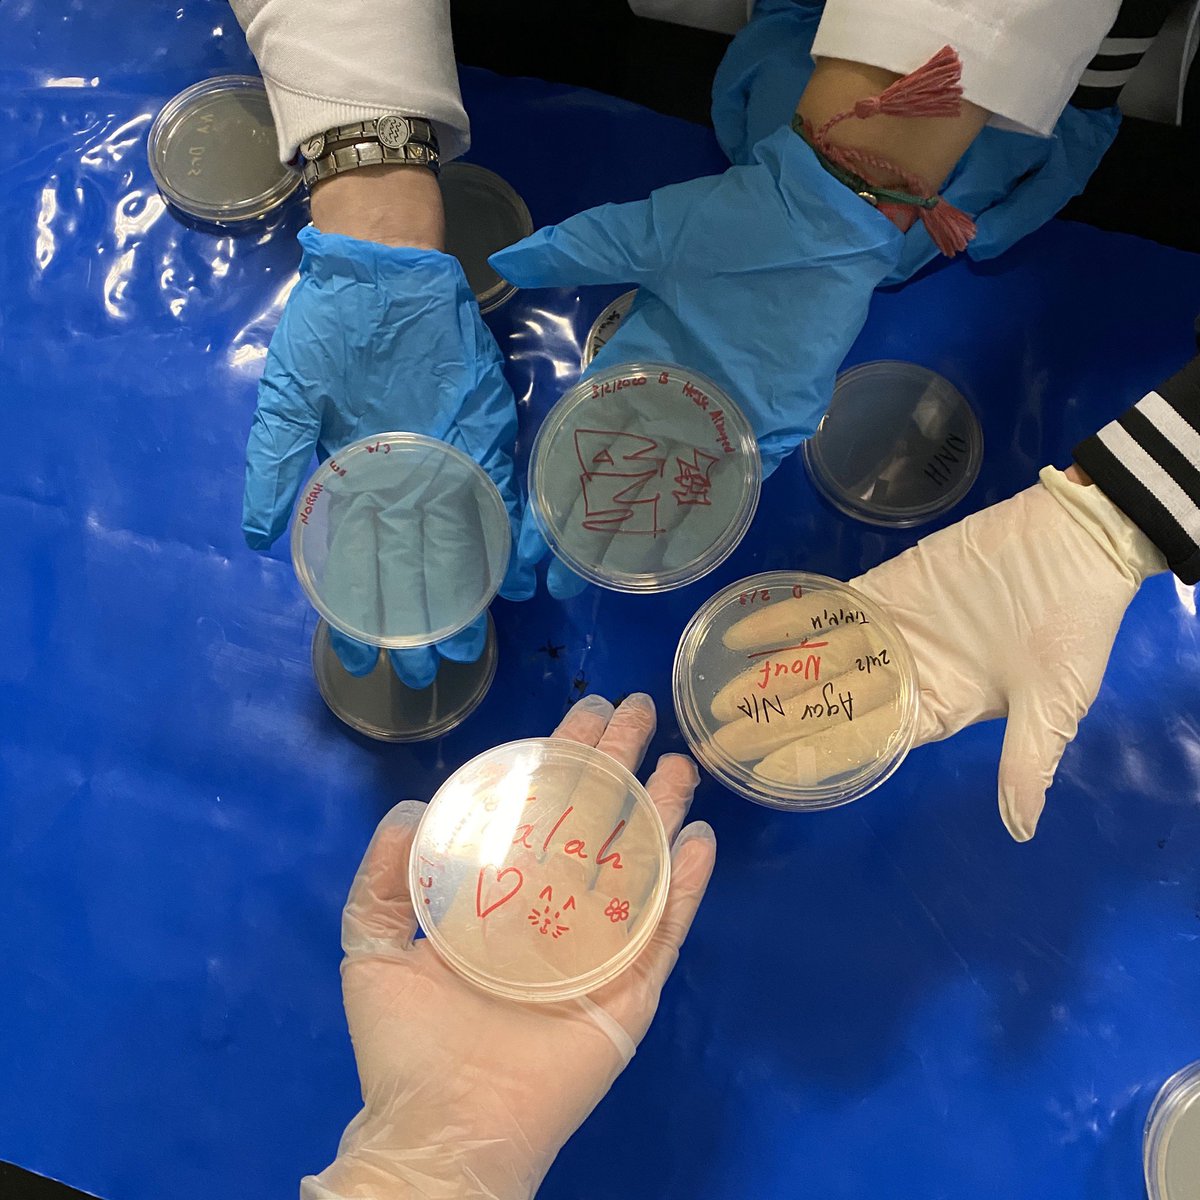
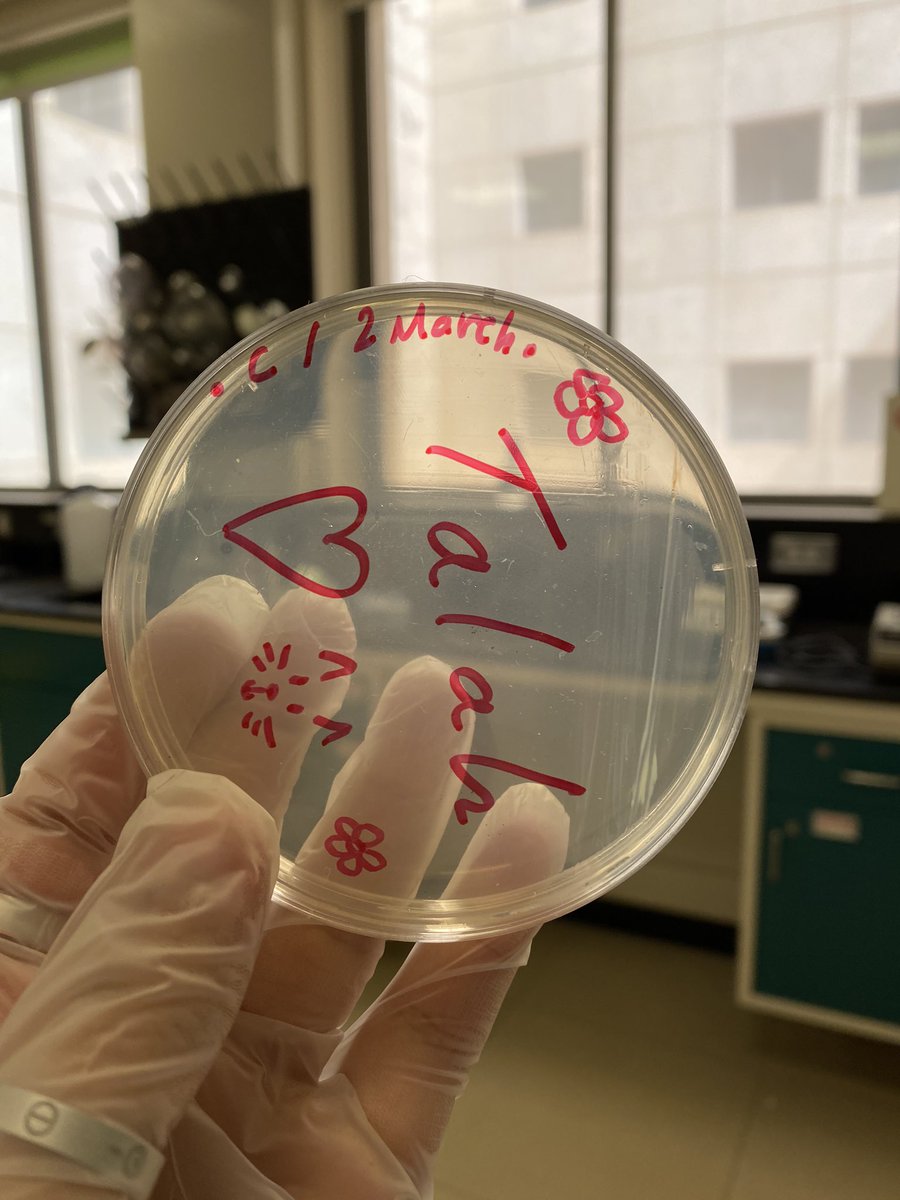
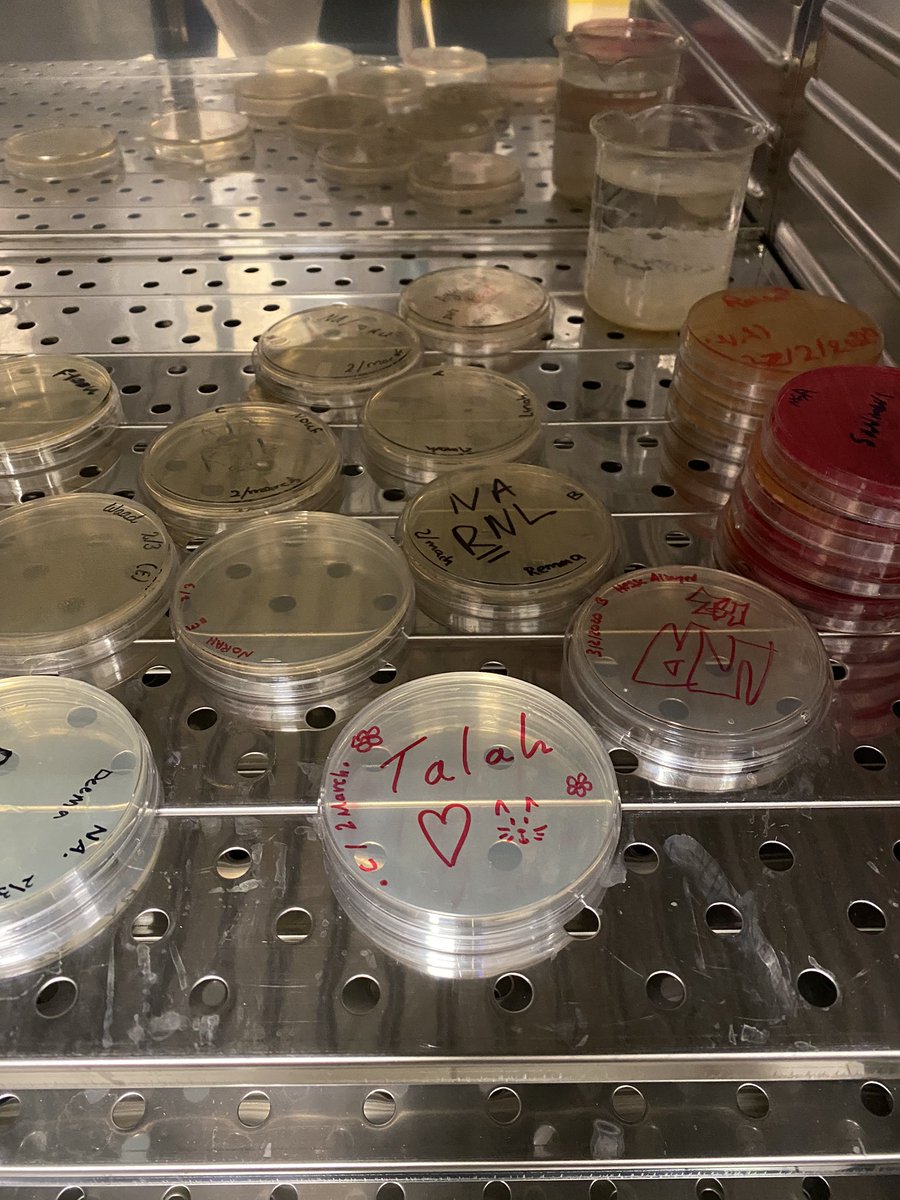
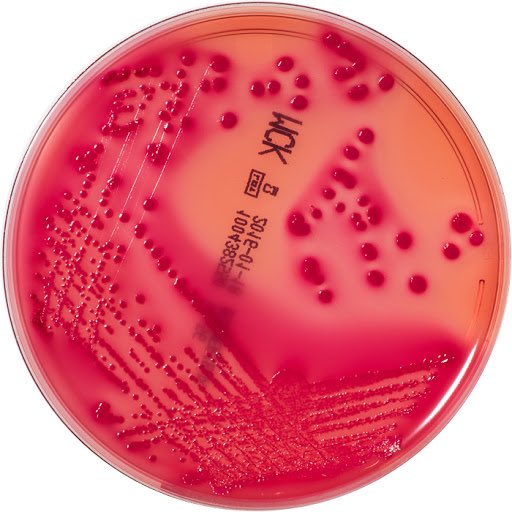

ﺍﻟﺤﻤﺪﻟﻠﻪ ﻣﺎﺗﻨﺎﻫﻰ ﺩﺭﺏٌ ﻭﻻ ﺧﺘﻢ ﺟﻬﺪٌ ﻭﻻ ﺗﻢ ﺳﻌﻲٌ ﺇﻻ ﺑﻔﻀﻠﻪ، ﺍﻟﺤﻤﺪﻟﻠﻪ ﻋﻠﻰ ﺍﻟﺒﻠﻮﻍ ﺛﻢ ﺍﻟﺤﻤﺪﻟﻠﻪ ﻋﻠﻰ التمام، الحمدلله الذي بنعمه تتم الصالحات??? #CLS439
-ثريد اشارككم فيها ايامي بتخصصي الجميل?✨
-ثريد اشارككم فيها ايامي بتخصصي الجميل?✨
#خارج_العتمة ?❤️❤️
جاري تحميل الاقتراحات...